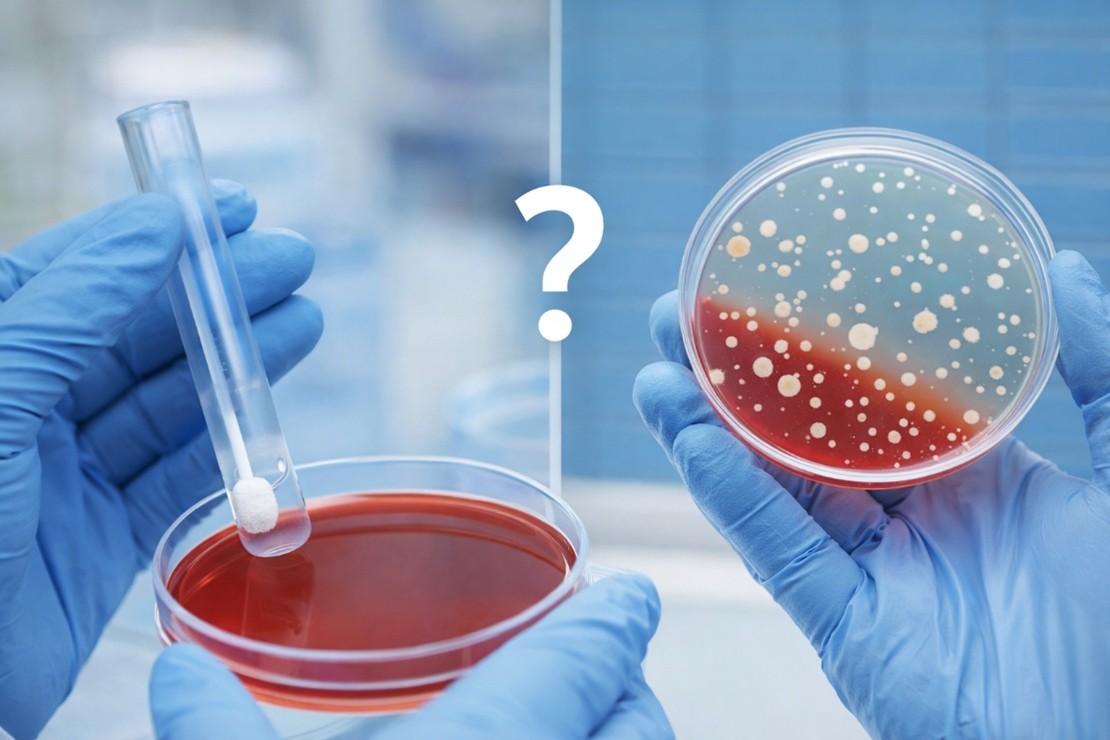

Чому «чистий мазок» не завжди означає відсутність інфекції
4 січня 2026
🧪Лабораторні дослідження є невіддільною частиною сучасної медицини та громадського здоров’я. Вони допомагають лікарю уточнити діагноз, обрати тактику лікування та оцінити ризики поширення інфекцій. Проте результати аналізів потребують правильного тлумачення.
Одним із поширених запитань є: чи означає «чистий» мазок повну відсутність інфекції?
Відповідь — не завжди.
ℹ️Бактеріологічний мазок — це метод, який дозволяє виявити певні види бактерій та оцінити мікрофлору. Водночас вірусні інфекції, внутрішньоклітинні збудники, деякі вибагливі або повільнозростаючі мікроорганізми можуть не визначатися при мікроскопії мазка. У таких випадках застосовуються інші методи лабораторної діагностики (бактеріологічний посів, молекулярно-біологічні, серологічні дослідження).
Певність результату безпосередньо залежить від дотримання правил підготовки пацієнта, правильного забору біологічного матеріалу та умов транспортування до лабораторії. Порушення будь-якого з цих етапів може призвести до того, що збудник не потрапить у зразок або буде представлений у недостатній кількості для виявлення.
- Попередній або самостійний приймання антибактеріальних препаратів, використання антисептиків чи місцевих лікарських засобів також можуть тимчасово зменшити кількість мікроорганізмів, змінити мікрофлору та ускладнити лабораторне виявлення збудника. При цьому інфекційний процес може зберігатися, а клінічні симптоми — продовжувати турбувати пацієнта.
- На різних етапах розвитку інфекції концентрація збудника змінюється. На ранній стадії він може ще не досягти рівня, що визначається лабораторно, а на пізній — зменшитися після часткового лікування або реакції імунної системи.
- У результатах мазка часто виявляють мікроорганізми, які є частиною нормальної мікрофлори людини. За певних умов — зниження імунітету, стресу, супутніх захворювань — вони можуть ставати причиною інфекційного процесу, навіть якщо мазок не демонструє явних патологічних змін.
Отже, «чистий» мазок не завжди виключає інфекцію. Лабораторні дані мають оцінюватися у комплексі з клінічними симптомами та результатами огляду лікаря, а за необхідності застосовуватись додаткові методи лабораторної діагностики
🔬Бактеріологічна лабораторія допомагає лікарю побачити невидиме, але правильний діагноз — це завжди командна робота.



